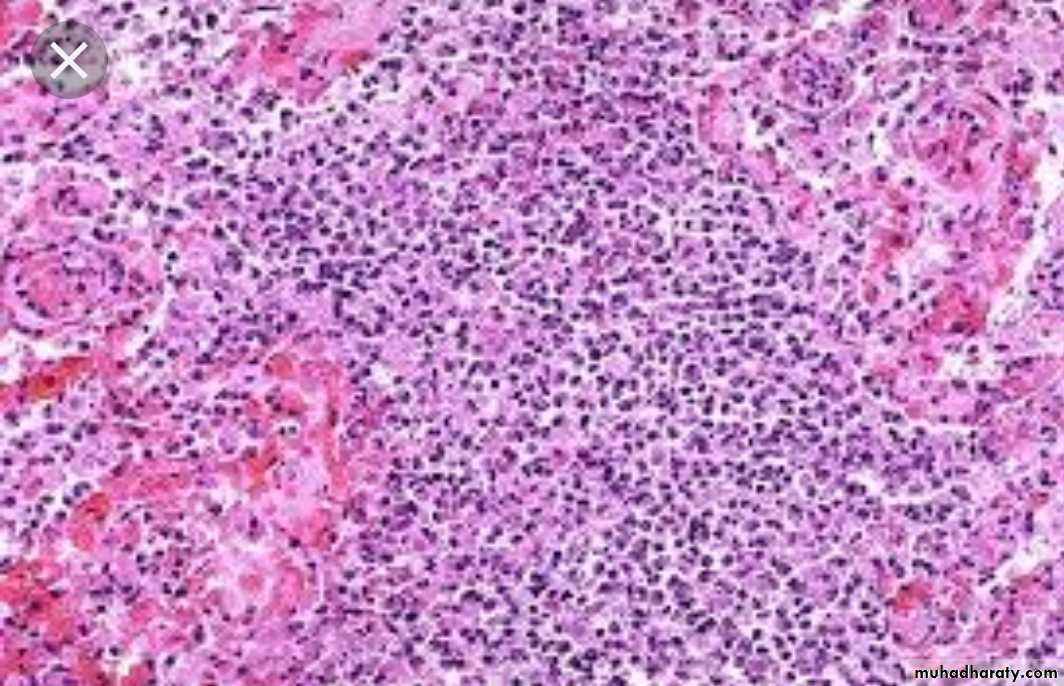

General Pathology of Infectious DiseasesPractical
Dr.Zahraa Osama YehyaDepartment of Pathology
Ninevah College of Medicine
Giant cell pneumonia
Measles , RSV , para inlf. V.Perinuclear clearing & basophilic staining cytoplasmic inclusion bodies (owl’s eye appearance) CMV infection
Catarrhal infection: affect mucus membrane/congested-odematous mucosa
Acute cattarhal gastritisPseudomembran. infection : characterized by formation of peudomembrane as in diphtheria.
Pseudomembranous colitis
Yellow-white mucosal plaques or pseudomembranes
Denuded epithelium with mucopurulent exudate erupts out of crypts to form a mushroom-like cloud of necrotic debris & neutrophils that adheres to surface
Grossly : a red swollen mass, the middle is filled with pus & debris, surrounding skin appears pink/red
Gas gangrene
Marked odema and necrosis of the involved muscle, wih large bullous/vesicles that may rupture producing serosanguinous exudateWet gangrene
Reddish/brown/black discoloration of the moist planter surface of the foot with skin ulceration, hemmorage & dirty necrotic base. No line of demarcation between dead & live tissuee.Dry gangrene
The affected foot is dry, brown/black with skin ulceration, however, a clear line of demarcation bet. Dead & live tissue is detected.Tuberculousis
a small sub pleural parenchymal lesion in the mid zone of the lung (Ghon focus),may spread to the hilar lymph nodes, both lesions are called Primary complex (Ghon complex).Well-defined granulomas are seen here. rounded outlines, contains several Langhans giant cells. Granulomas are composed of transformed macrophages called epithelioid cells along with lymphocytes, occasional PMN's, plasma cells, and fibroblasts. The localized, small appearance of these granulomas suggests that the immune response is fairly good.
• Tubercular lymphadenitis
This is an acid fast stain of Mycobacterium tuberculosis (MTB).
Note the red rods--hence the terminology for MTB in histologic sections or smears: acid fast bacilli.Secondary TB
usually occurs at the apex of the lung with minimal lymph node involvement. There is marked damage in the lung parenchyma with cavity formation
When the immune response is poor or is overwhelmed by an extensive infection, then it is possible to see the gross pattern of granulomatous disease seen here. This is a "miliary" pattern of granulomas because there are a multitude of small tan granulomas, about 2 to 4 mm in size, scattered throughout the lung parenchyma.